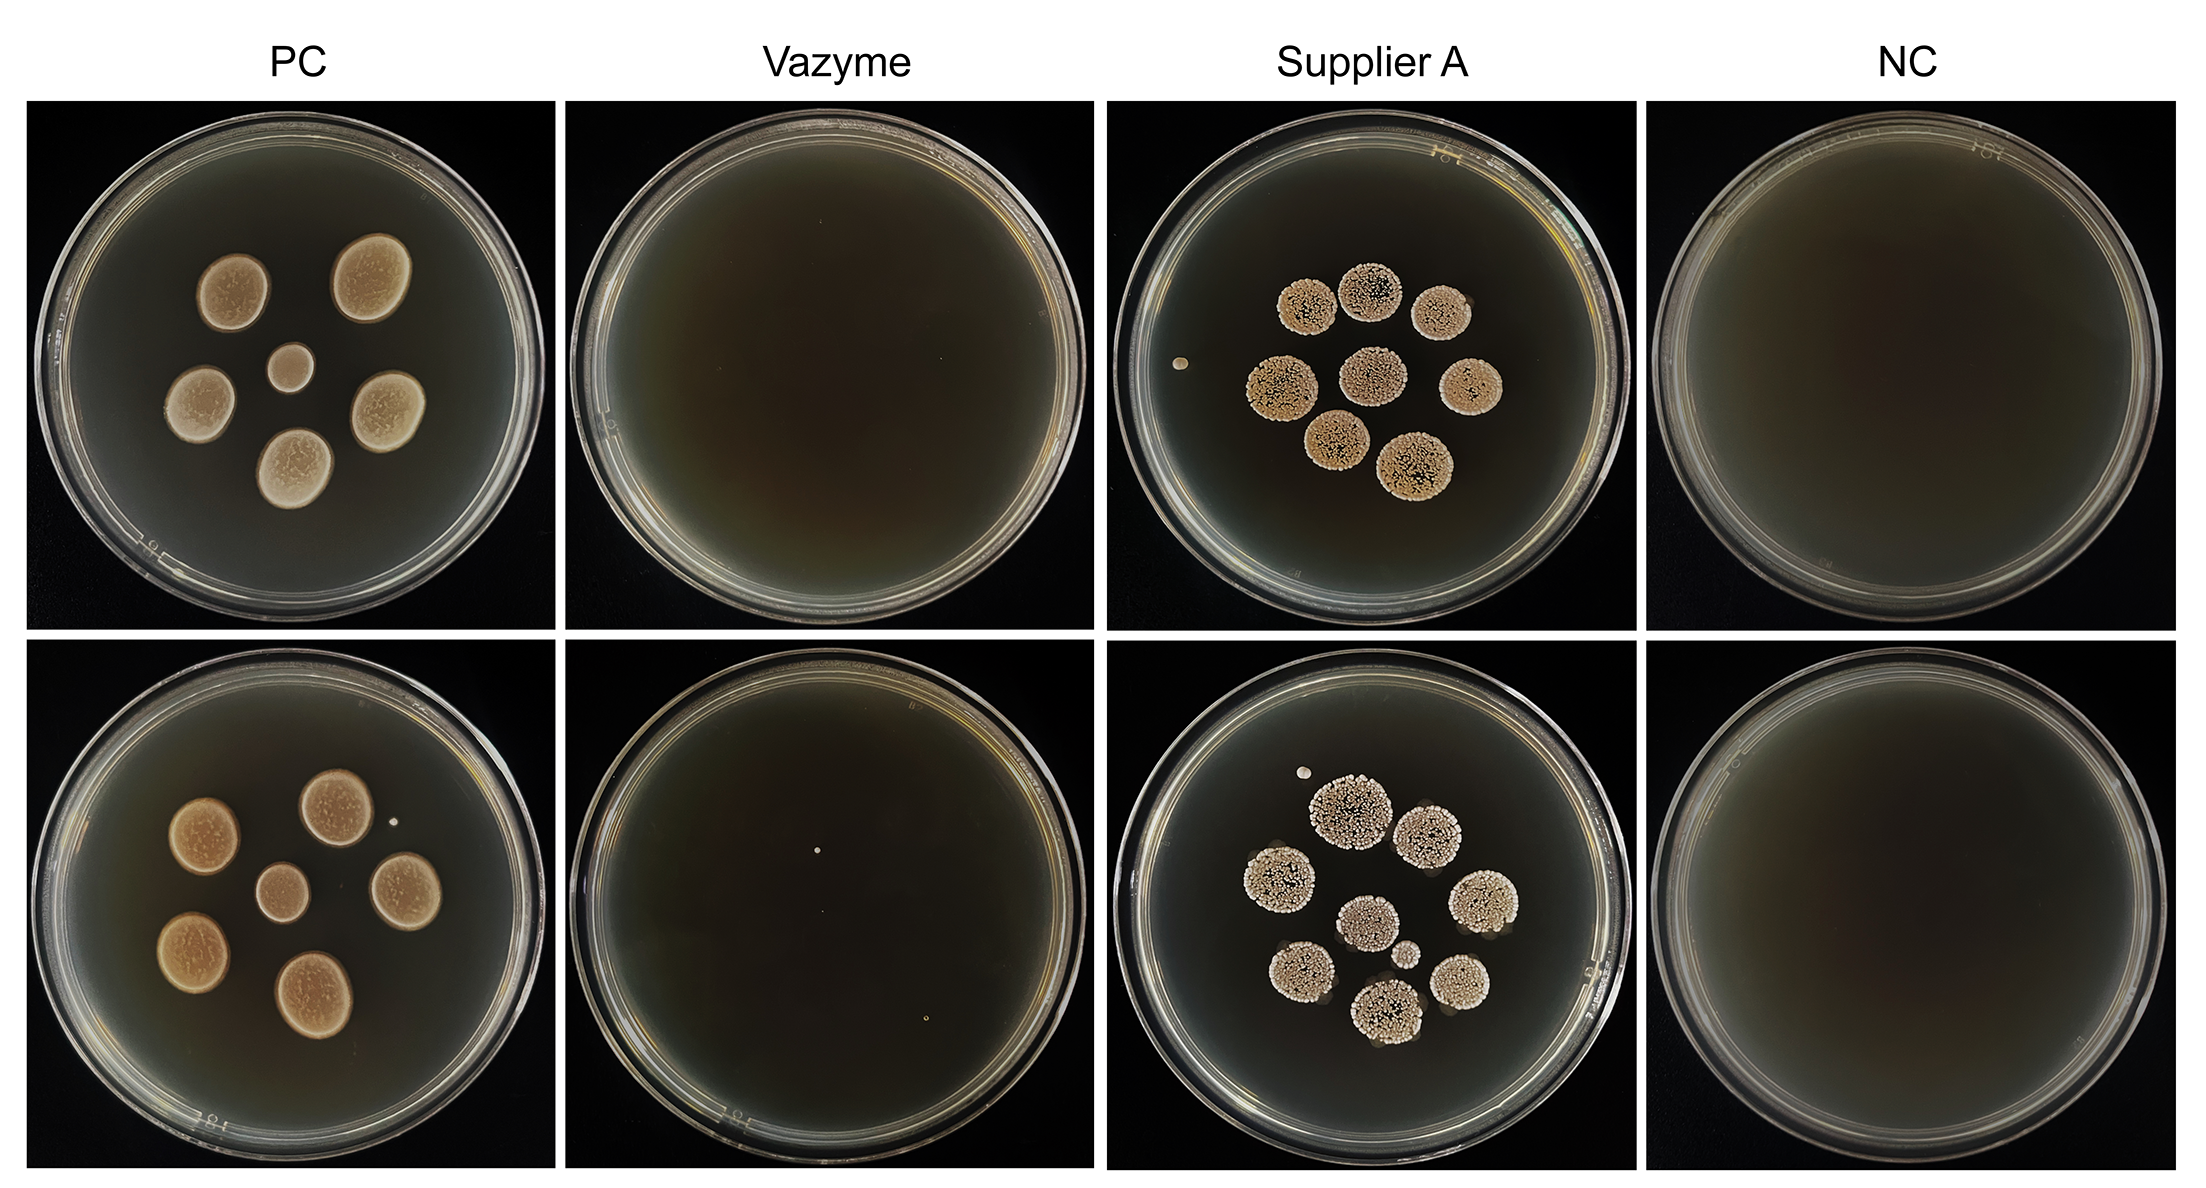
产品细节图片1
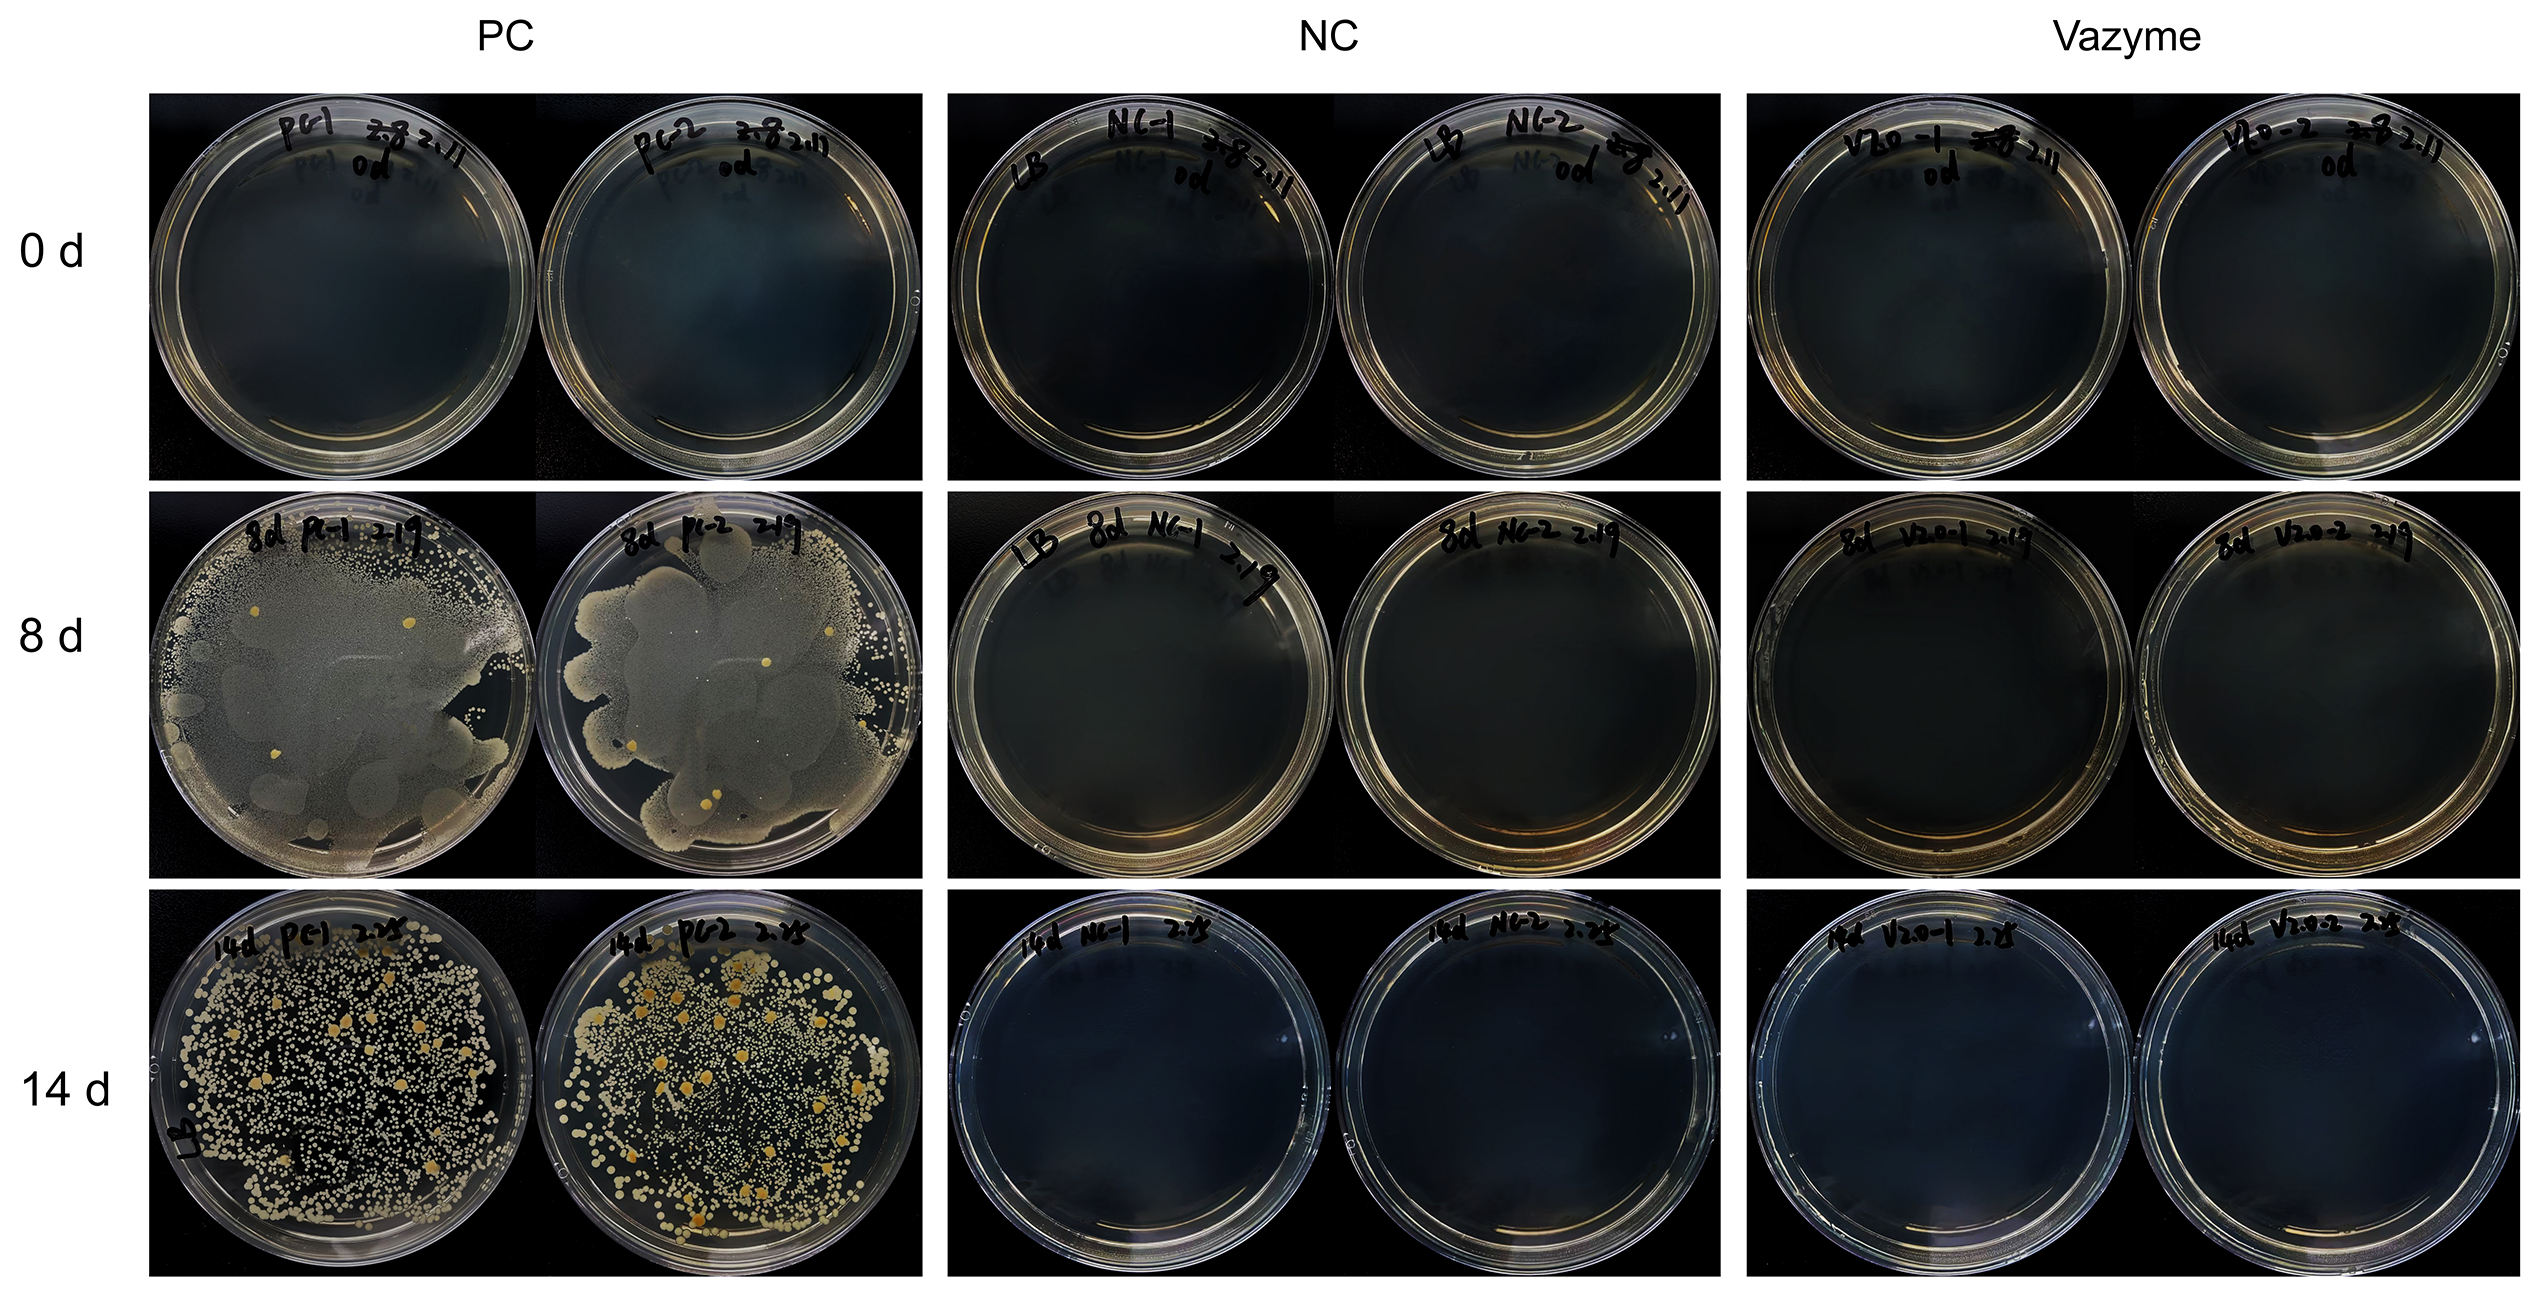
产品细节图片3

相关产品推荐更多 >
万千商家帮你免费找货
0 人在求购买到急需产品
- 详细信息
- 文献和实验
- 技术资料
- 规格:
100 ml/500 ml
| 规格: | 100 ml | 产品价格: | ¥380.0 |
|---|---|---|---|
| 规格: | 500 ml | 产品价格: | ¥1580.0 |
Water Disinfectant (500 ×)
水浴抑菌剂(500 ×)
细胞健康状态,“净”在点滴之间
产品应用
用于清除水浴锅、培养箱水盘中的水源污染,包括细菌、真菌、支原体、藻类、部分病毒等。
产品描述
细胞污染是细胞实验常遇到的问题,会导致细胞生长受阻、基因表达改变、实验结果失真,造成时间和经济损失,甚至生物安全风险。水浴锅和培养箱是细胞培养过程中经常要用到的仪器,其中的水体频繁处于37℃环境,为细菌、真菌等微生物提供了有利的生长条件,是细胞污染的潜在来源。本产品安全无味无腐蚀性,直接按比例添加在水浴锅或培养箱水盘的水中,可保持水体洁净、无菌,有效、针对性地对细菌、真菌、支原体、藻类、部分病毒等微生物进行生长控制和清除,能维持水浴锅和培养箱水盘无菌状态7 - 14天,有效减少细胞污染。
产品优势
安全无味、起效迅速、持续抑菌时间长、无设备腐蚀性。
性能展示
1. 针对细菌、真菌的性能检测
图1 抑制细菌真菌测试结果
在细菌真菌混合悬液 (OD600 = 0.9)中分别加入Vazyme #D301和主流品牌抑菌剂,作用1 h后取样100 μl点板,30℃培养48 h,结果显示,D301能有效控制细菌真菌生长。
2. 针对支原体的性能检测

图2 抑制支原体测试结果
取100 μL支原体污染的细胞培养液上清(U373细胞生长6 d后取上清过0.45 μm滤膜)接种至DMEM完全培养基中,分别加入Vazyme #D301和主流品牌抑菌剂,置于37℃二氧化碳培养箱培养。根据0 d、1 d、4 d、7 d时间梯度取样后进行qPCR检测。结果显示,D301能有效控制支原体生长。
3. 持续抑菌性能检测
图3 持续抑菌测试结果
将Vazyme #D301加入水浴锅的水中,每天打开水浴锅盖子并进行37℃水浴0.5 d,根据0 d、8 d、14 d时间梯度取样点板培养。结果显示,D301能维持水浴锅水体无菌状态至少14 d。
4. 设备腐蚀性检测

图4 设备腐蚀性测试结果
将直径20 mm,厚1 mm不锈钢金属片浸泡在10倍工作浓度Vazyme #D301中,置于37℃ 21 d。结果显示,浸泡前后金属片质量未发生变化,金属片未发生锈蚀,D301对不锈钢设备无腐蚀性。
组分&说明
储存条件
15 ~ 25℃
风险提示:丁香通仅作为第三方平台,为商家信息发布提供平台空间。用户咨询产品时请注意保护个人信息及财产安全,合理判断,谨慎选购商品,商家和用户对交易行为负责。对于医疗器械类产品,请先查证核实企业经营资质和医疗器械产品注册证情况。
文献和实验Synthesis of Peptide‐Oligonucleotide Conjugates by Diels‐Alder Cycloaddition in Water
on a 2‐Chlorotrityl Chloride Resin Basic Protocol 4: Preparation of Peptide‐Oligonucleotide Conjugates by Diels‐Alder Cycloaddition in Water Alternate Protocol 2: Preparation of Cysteine‐Containing Peptide
How to Make Simple Solutions and Dilutions
than the desired dilution factor value. Example 2: Suppose you must prepare 400 ml of a disinfectant that requires 1:8 dilution from a concentrated stock solution with water. Divide the volume needed by the dilution factor (400 ml / 8 = 50 ml) to determine
Aseptic Technique and Good Cell Culture Practice
(2.5g/l) 1% formaldehyde based disinfectant e.g.Virkon,Tegador 70% ethanol in water (Prod. No. R8382 ) Equipment Personal protective equipment (sterile gloves, laboratory coat, safety visor) Microbiological safety












